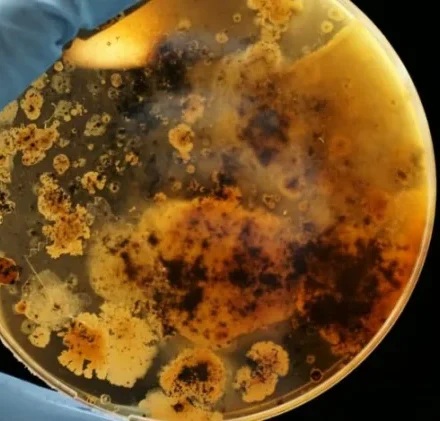

Гаур — крупнейший представитель рода настоящие быки
Гаур (Bos frontalis), также известный, как индийский бизон - крупнейший из сохранившихся в наши дни представитель рода настоящие быки (Bos), родом из Южной и Юго-Восточной…
Читать далееТОП 10 самых умных пород собак в мире
Взгляните на наш список, чтобы увидеть, относиться ли ваша собака к одной из самых умных пород собак в мире.
Читать далееТОП 10 Лучших охотничьих пород собак на планете
Если вы ищете верного спутника, для помощи на охоте, эти собаки самые лучшие варианты.
Читать далееСамые опасные породы собак
Существует множество факторов, которые способны присвоить собаке титул «опасная», но большинство критиков и исследователей не могут прийти к единому мнению об этих…
Читать далееСамые необычные явления природы, с фото и описанием
Трудно поверить, но есть явления природы, которые ученые до сих пор не могут объяснить.
Читать далееСамые красивые места природы в мире, с фото, названием и описанием
Помните! Все списки "чудес природы" являются субъективными и каждый вправе сам выбирать, что для него чудо, а что обыденное явление.
Читать далееТОП 10 самых опасных и активных вулканов в мире
Вулканическая активность является регулярным и суровым напоминанием, что планета, на которой мы живем, имеет постоянно меняющуюся…
Читать далееТОП 10 самых больших (широких) водопадов в мире
Этот ТОП 10 основан на ширине водопадов, а не высоте или объеме. Каждый водопад из списка замечательный в своем роде.
Читать далееСамые красивые горы в мире
Когда вы думаете о вдохновляющих пейзажах, что первое приходит на ум? Каждый человек имеет разные предпочтения, но большинство людей сразу же представят себе горные…
Читать далееТОП 10 самых опасных животных в мире
Когда вы путешествуете пешком или плаваете на природе, какие существа вызывают у вас самый большой страх?
Читать далееТОП 10 самых больших пород собак в мире — названия, фото и краткое описание
Независимо от того, является ли большая порода подходящей для вас, вы все равно можете узнать больше информации об этих огромных красавцах. Вот некоторые из крупнейших и самых популярных пород собак в…
Читать далееНайден ответ: что появилось раньше, курица или яйцо?
Что было раньше, курица или яйцо? Без курицы нет яйца, а без яйца соответственно курицы. Этого достаточно, чтобы скрутить вашу голову.
Читать далееТОП 10 самых быстрых животных на планете
Как быстро вы можете бежать? Исследования показывают, что теоретически человек способен развивать скорость около 64 км/ч, но на практике средняя спринтерская скорость не превышает 20-25…
Читать далееПрирода Украины
Дикая природа Украины включает в себя широкое разнообразие флоры и фауны. Животный мир Украины насчитывает около 45 000 видов, включая области в Черном и Азовском…
Читать далее